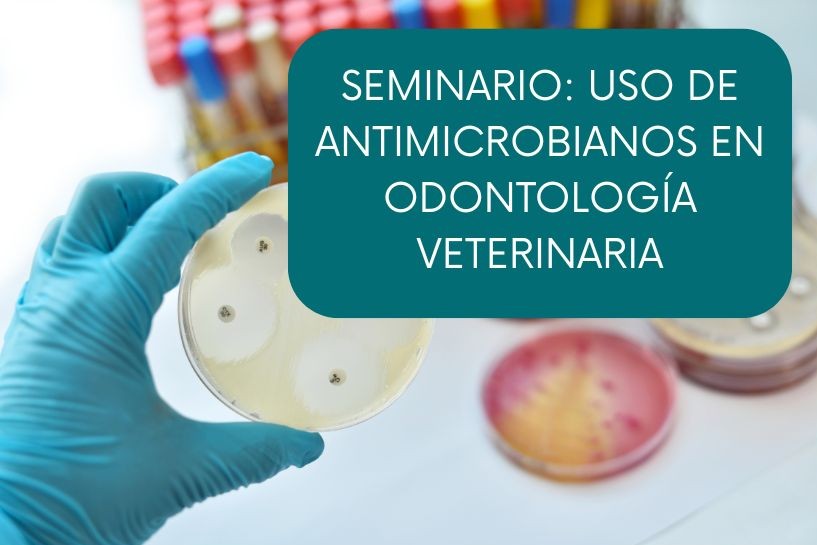

Para celebrar la Semana Mundial de Concientización sobre la RAM, WSAVA te invita a un seminario web especial sobre el uso responsable de antibióticos en odontología veterinaria. 19 de noviembre, 8:00 p. m. EST (1:00 a. m. UTC, 20 de noviembre). TAGS: Seminario web. RAM. Odontología veterinaria. Medicina veterinaria.
Esta conferencia explorará las recomendaciones más recientes sobre el uso de antimicrobianos, comenzando con las nuevas investigaciones en bacteriología oral y profundizando en la selección adecuada de antibióticos.
La sesión también abordará las pautas preoperatorias, intraoperatorias y postoperatorias, así como recomendaciones para el manejo de diversas patologías.
Nuestros oradores expertos, el Dr. J. Scott Weese (DVM, DVSc, DACVIM) y el Dr. Brook Niemiec (DVM), brindarán conocimientos prácticos para ayudar a los profesionales veterinarios a tomar decisiones informadas y desempeñar un papel activo en la lucha contra la resistencia a los antimicrobianos.
Unite a nosotros el 19 de noviembre a las 20:00 h EST y participá en la conversación global sobre el uso responsable de antibióticos.
Fuente: WSAVA

No hay comentarios aún.